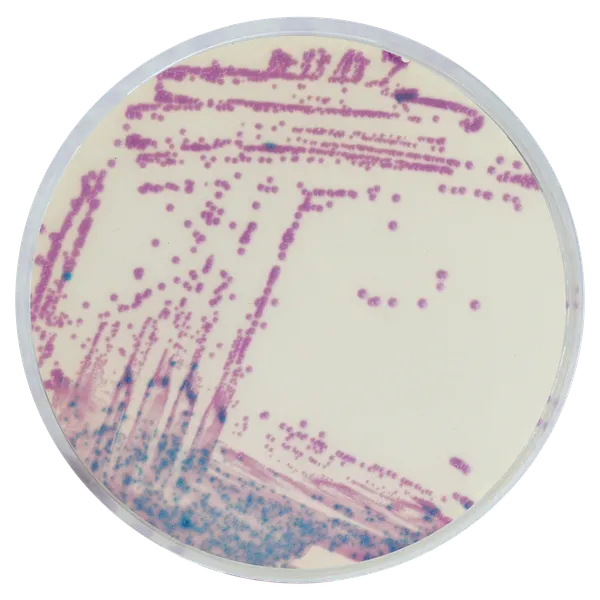
LIM RambaQUICK™ StrepB

Hình thái khuẩn lạc

Liên cầu khuẩn nhóm B
Màu tím nhạt

Các vi sinh vật khác
Màu xanh, không màu hoặc bị ức chế
Hiệu năng
Hiệu năng
CDC khuyến cáo phụ nữ mang thai nên được xét nghiệm ở tuần 35 đến 37 của thai kỳ để kiểm tra tình trạng mang Group B Streptococcal (GBS) thông qua nước canh tách chọn lọc của mẫu gạc âm đạo/ trực tràng, sau đó nuôi cấy phụ. Tuy nhiên, các công thức nước canh tách chọn lọc không được thiết kế để ức chế Enterococci, thường là một phần của hệ vi sinh trực tràng và có thể che giấu sự phát triển của GBS, gây kết quả âm tính giả.
LIM RambaQUICK™ StrepB là nước canh tách chọn lọc được thiết kế để giảm đáng kể sự phát triển của Enterococci, đồng thời cho phép GBS phát triển, từ đó nâng cao độ nhạy của phương pháp sàng lọc trước khi sinh.
So với phương pháp LIM cổ điển + nuôi cấy phụ:
1. Ức chế hầu hết Enterococci: LIM RambaQUICK™ StrepB là nước canh tách chọn lọc được thiết kế để giảm đáng kể sự phát triển của Enterococci, đồng thời cho phép GBS phát triển, từ đó nâng cao độ nhạy của phương pháp sàng lọc trước khi sinh.
2. Inoculation của nước canh: Phương pháp cổ điển khuyến nghị ủ nước canh qua đêm cho LIM cổ điển. LIM RambaQUICK™ StrepB cũng có thể được sử dụng với ủ qua đêm, nhưng có sự phân biệt tối ưu chỉ trong 6 giờ như được khuyến nghị trong nghiên cứu của Phương pháp Dr. Poisson.
Nghiên cứu: Lọc trước sinh nhóm âm đạo / trực tràng. Lọc streptococci: cải thiện giai đoạn tách chọn lọc bằng nước canh phụ gia RambaQUICK StrepB; D. Poisson et al. Centre Hospitalier Régional Orleans, Pháp; Journal de Méthodes de Microbiologie 89 (2012) 107-109 doi:10.1016/j.mimet.2012.02.012
3. Dễ dàng giải thích đĩa nuôi cấy phụ: Dễ đọc đĩa CHROMagar™ StrepB nhờ màu sắc đậm của khuẩn lạc màu tím nhạt.
Thành phần
Tài liệu kỹ thuật
Công bố khoa học
2014
Comparison of culture-based methods for Group B Streptococcus detection in screening samples from pregnant women
? Publication2012
Prepartum vaginal/anorectal Group B Streptococcus screening: Improvement of the enrichment step by the broth additive RambaQUICK StrepB
? Publication

Xem thêm